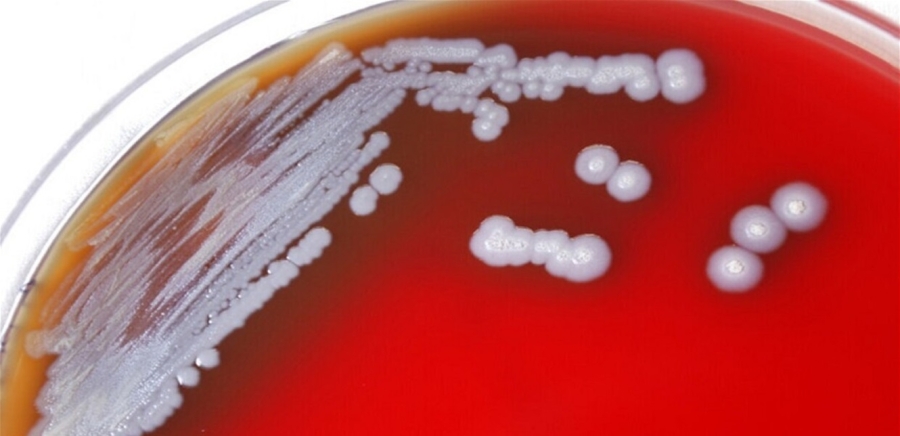

المومني :إجراء القرعة الإلكترونية لاختيار مكلفي خدمة العلم لعام 2026 الساعة الخامسة من مساء يوم الاثنين
المومني :إجراء القرعة الإلكترونية لاختيار مكلفي خدمة العلم لعام 2026 الساعة الخامسة من مساء يوم الاثنين
 محافظ العقبة: غرفة العمليات الرئيسة تعمل على مدار الساعة لمتابعة الحالة الجوية
محافظ العقبة: غرفة العمليات الرئيسة تعمل على مدار الساعة لمتابعة الحالة الجوية
 أمانة عمّان: الطرق سالكة والعمل الميداني مستمر رغم الأمطار الغزيرة
أمانة عمّان: الطرق سالكة والعمل الميداني مستمر رغم الأمطار الغزيرة
 سلطة البترا تؤكّد خلو الموقع الأثري من الزوار حرصًا على السلامة خلال المنخفض
سلطة البترا تؤكّد خلو الموقع الأثري من الزوار حرصًا على السلامة خلال المنخفض
 شحادة: 220 قرارًا اقتصاديًا خلال 444 يومًا لدعم نمو يصل إلى 3.2%
شحادة: 220 قرارًا اقتصاديًا خلال 444 يومًا لدعم نمو يصل إلى 3.2%
 الترخيص المتنقل "المسائي" للمركبات في برقش غدا
الترخيص المتنقل "المسائي" للمركبات في برقش غدا
 العدوان يتفقد مراحل تنفيذ المسح الوطني للشباب في البلقاء
العدوان يتفقد مراحل تنفيذ المسح الوطني للشباب في البلقاء
 موانئ العقبة: لا تأثير على حركة الملاحة والمناولة
موانئ العقبة: لا تأثير على حركة الملاحة والمناولة
 علي علوان يتوج بجائزة أفضل لاعب بعد تألقه أمام الكويت
علي علوان يتوج بجائزة أفضل لاعب بعد تألقه أمام الكويت
 سلامي: لاعبي "النشامى" دخلوا مواجهة الكويت بجدية وتركيز كبيرين
سلامي: لاعبي "النشامى" دخلوا مواجهة الكويت بجدية وتركيز كبيرين
 رئيس سلطة العقبة يتابع الاستعدادات للحالة الجوية
رئيس سلطة العقبة يتابع الاستعدادات للحالة الجوية